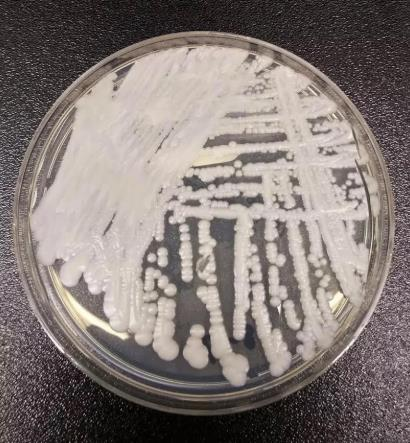

耳念珠菌蔓延全美,内华达州、加州最严重世界日报
抗药性且能致命的耳念珠菌(Candida auris)感染,正引起关注。联邦疾病防治中心(CDC)的追踪数据显示,2025年至少有7000人受感染,主要在医院、护养院及其他医疗院所蔓延,并以内华达州和加州的感染案例最多。过半数患者,平均年龄在60至64岁之间,并且需要输血。
美国疾病防治中心(CDC)展示在培养皿中的「耳念珠菌」,既具抗药性且能致命。(美联社)
耳念珠菌是一种真菌,于2016年首次在美国发现,并在过去几年中迅速传播。该菌可以在物体表面存活良久,然后透过导管、呼吸管或静脉输液管传播给患者。
某些菌株被视为超级细菌,因为它们对所有一般用于治疗真菌感染的药物都具抗药性。虽然健康人士或能自行抵抗感染,但在医疗院所等真菌传播环境中,由于内居者往往患病,这种真菌感染可以致命。
南卡罗来纳大学流行病学及生物统计学助理教授诺兰(Melissa Nolan)向媒体Nexstar说:「如果感染这种对任何治疗都具抗药性的病原体,医护就没有任何疗法可帮助对抗它,只能靠病患自己的免疫力。」
抗药性令这种真菌特别难以控制。根据CDC报告,2025年超过一半的州,报告耳念珠菌感染的临床病例。截至2025年底(尚缺一周数据),共录得的病例总数,已接近2024年创纪录的逾7500宗。最多的州,为内华达州及加州,分别为1605及1524宗。
今年7月发表的一项研究,聚焦探视内华达州和佛罗里达州的耳念珠菌感染患者,发现过半病患需要入住加护病房,超过三分之一的患者需要通气机械设备。亦有逾半病人需输血,他们的平均年龄在60至64岁之间。 CDC曾估计:「根据有限数量的患者信息,30%至60%的耳念珠菌感染者死亡。不过,这些人中许多还患有其他严重疾病,这也增加了死亡风险。」
一些科学家推测,气候变迁促进耳念珠菌及其类似病原体的传播。约翰霍普金斯大学微生物学家卡萨德瓦尔(Arturo Casadevall)告诉美联社,从历史观察,真菌难以在温暖的人体体温下生存。然而,随着气候变暖,真菌也在适应中。
他说:「由于体内的高温度,人类对环境真菌有极强的抵抗力。但是,如果全球变暖,真菌也开始适应更高的温度,那么一些真菌……将会达到我所说的温度屏障,那就可以在人体内存活了。」
■ 耐药真菌在多州蔓延,致死率极高(组图)